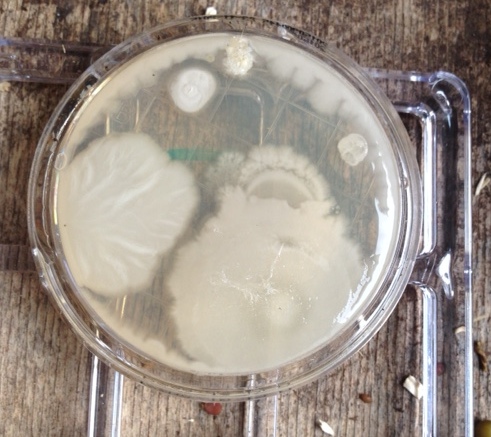

Vroegtijdige afbraak BioSubstraat lijkt onder controle
Het plantaardige materiaal (in casu hennep) dat de matrix vormt van het BioSubstraat is gevoelig voor biologische afbraak, interessant vanuit recycling oogpunt echter vroegtijdige biodegradatie leidt tot functie- en structuurverlies. Hoe dit dilemma op te lossen nl. een biobased vertrager van biologische afbraak.

Kiemtest Fytotoxiciteittest
Voorbereidende experimenten door Telson bv, Living Foods bv, HempFlax bv, Parx Plastics bv en CropEye hebben veelbelovende effecten aangetoond van een bepaalde fractie uit pyrolyse olie, van een coating met geïmmobiliseerde zink ionen en van chitosan uit doppen van garnalen. Tegelijkertijd is ook indicatief een toets op fytotoxiciteit uitgevoerd. In een uitgebreide proef (december 2015) worden “de beste concentraties” uitgebreid getest.


By clicking on the posters above, you can view or download the posters
Bent u geïnteresseerd? neem dan contact op met:
Daan Kuiper -
BioEco Congress Papenburg 20-21 maart 2019
Lees het ARTIKEL over het congres in het vakblad Agro & Chemie. For English click here

By clicking on the poster, you can view or download the poster

Publicaties:
Website Bio-economie van Eems Dolland Regio: www.bioeco-edr.eu/nl/biosubstraat
Presentatie getoond op 27-01-2016 tijdens de pitch van het grote TKI overleg in Den Bosch
GTT Magazine nr 4, september 2011: Question&Answere
Groentennieuws: artikel over 'CropEye zoekt telers voor test in 2013'
"Routekaart Tuinbouw in de Biobased Economy" blz. 12

